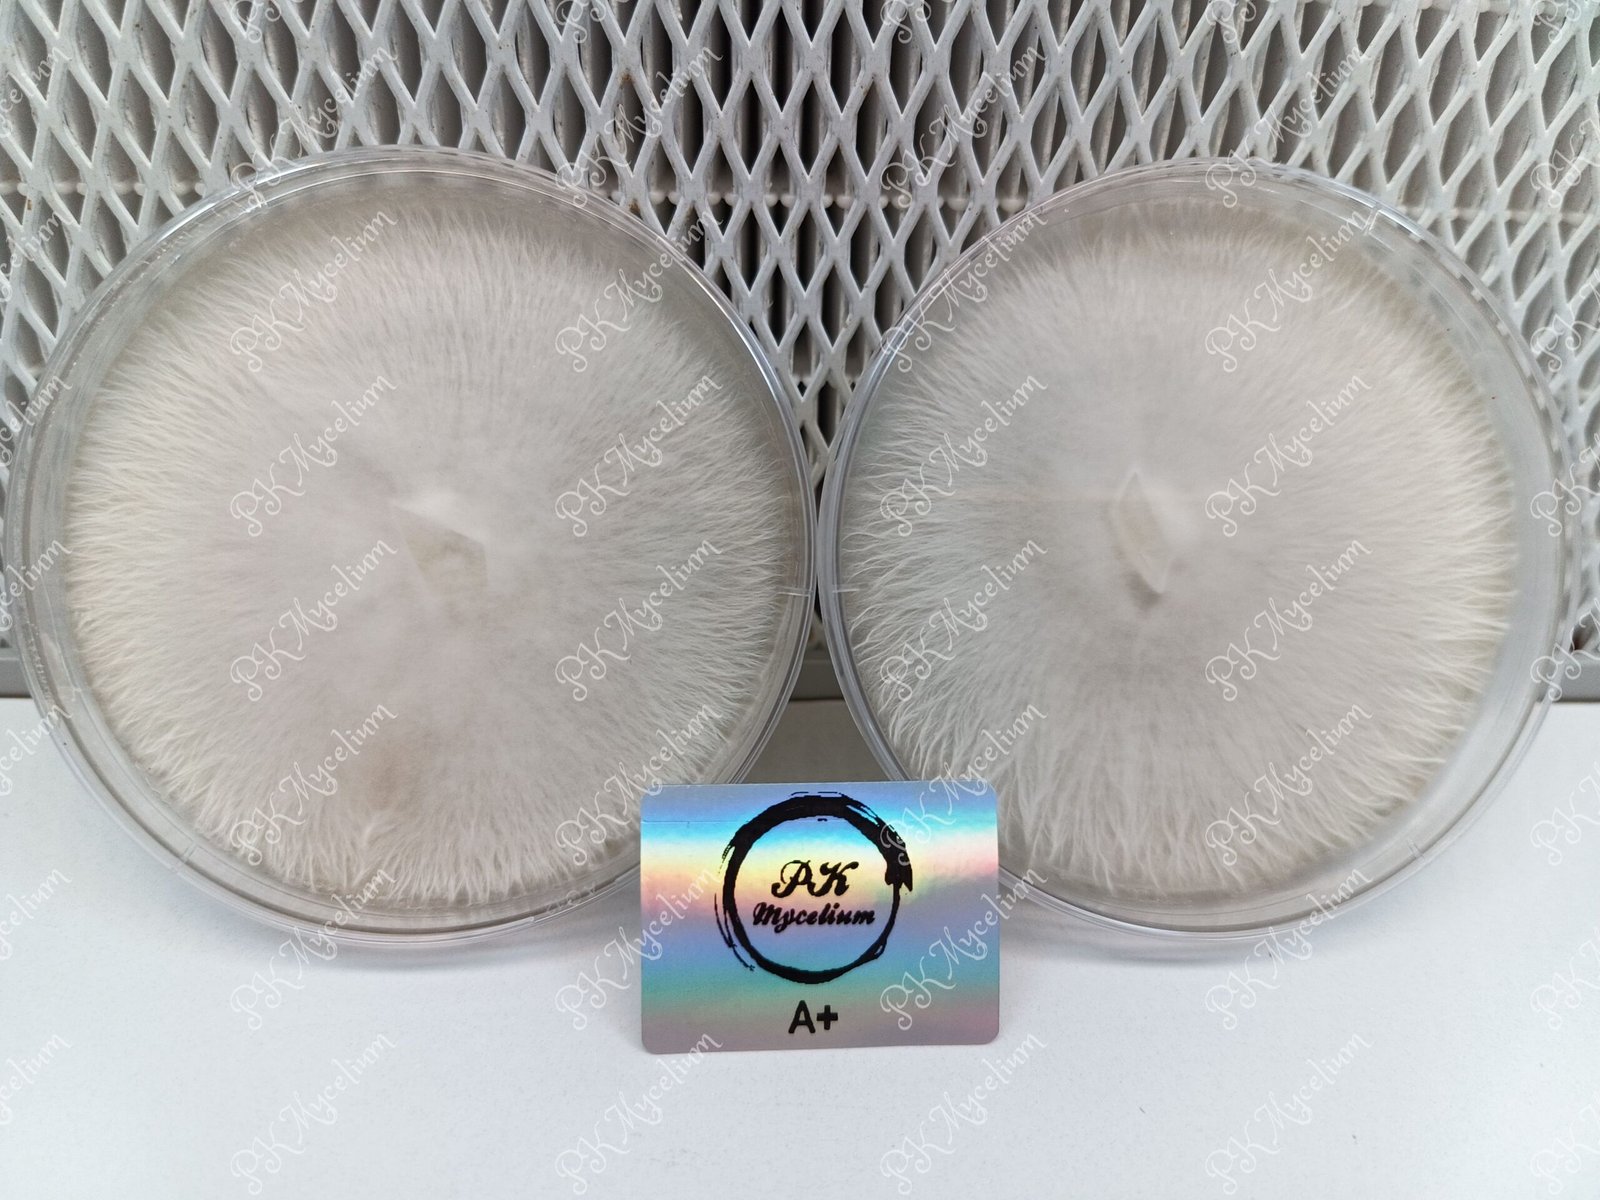

La Placa Petri de A+ es el punto de partida ideal para trabajar con esta cepa a nivel de laboratorio. Perfecta para aislamientos, expansión de micelio y conservación genética de alta pureza.
A+
La Cubensis Clásica de Crecimiento Resistente y Estabilidad Comprobada
Origen y Características Históricas
Creador y linaje:
La A+ fue desarrollada por «Mr. G» e introducida en la comunidad micológica a través de Shroomery.org. Se cree que deriva de una cepa de Sudamérica o Sudeste Asiático, adaptada a entornos tropicales y subtropicales. Produce sombreros medianos a grandes de color dorado a marrón claro que pueden desarrollar verrugas al madurar, tallos delgados y blancos con tendencia a azulear al manipularse, y láminas que pasan de claras a marrón violáceo en madurez. Es reconocida por su excepcional producción de esporas, lo que la hace muy popular entre vendedores y coleccionistas.
Nombre y popularidad:
El nombre «A+» refleja su reputación de confiabilidad y buen rendimiento. Se popularizó rápidamente en la comunidad micológica por su estabilidad, alta producción de esporas y facilidad de cultivo relativa.
Difusión internacional:
A través de Shroomery.org y comunidades underground de micología, la A+ se extendió globalmente, convirtiéndose en cepa de referencia para vendedores de esporas y cultivadores principiantes e intermedios.
Importancia cultural:
La A+ representa una introducción sólida al mundo de las cubensis: accesible en el cultivo, con potencia por encima de la media y una generosidad en producción de esporas que la ha consolidado como pilar de la comunidad psiconáutica online.
Cultivo y Rendimiento
Dificultad:
Principiante a intermedio.
Condiciones recomendadas:
- Colonización: 24–28 °C
- Fructificación: 20–24 °C
- Humedad: 90–95 %
- Ventilación: buena circulación de aire para evitar deformaciones y exceso de CO₂
- Luz: indirecta, suficiente para guiar el crecimiento de los cuerpos fructíferos
Rendimiento:
Bueno bajo condiciones óptimas. Los primeros flushes son los más productivos; la contaminación puede dificultar los flushes posteriores. Alta producción de esporas en todos los flushes.
Potencia y Efectos
Potencia:
Por encima de la media.
Efectos típicos:
- Euforia clara y bien definida
- Claridad mental y percepción sensorial aumentada
- Visuales moderados
- Experiencias introspectivas accesibles
- Sensación de bienestar y ligereza
Perfil equilibrado y accesible, con una potencia superior a la media que la sitúa por encima de las cubensis más básicas.
Advertencias y Dosis Sugerida
- Empezar con dosis moderadas dado que su potencia está por encima de la media de las cubensis estándar.
- No combinar con alcohol ni fármacos incompatibles. Precaución para personas con condiciones médicas o medicación activa.
- Mantener siempre un entorno seguro y cómodo.
Aplicaciones Terapéuticas y Uso
- Sesiones de introspección inicial y exploración creativa.
- Microdosis para mejora del estado de ánimo y claridad mental suave.
- Ideal para usuarios que dan sus primeros pasos más allá de las cubensis más básicas.
Métodos de Consumo y Preparación
- Té de psilocibina: reduce la náusea y facilita un inicio más suave.
- Lemon Tek: potencia y acelera los efectos — reducir la dosis un 20 % respecto a la ingestión directa.
- Ingestión seca: método estándar, calcular bien la dosis dado su perfil por encima de la media.
Plano Espiritual
En el plano espiritual, la A+ ofrece una puerta de entrada accesible y bien definida al mundo psicodélico. Sus experiencias se caracterizan por una apertura clara de la percepción, con momentos de ligereza y reflexión que invitan a la exploración interna sin abrumar. Es apreciada por quienes buscan conectar con su entorno y consigo mismos de forma tranquila y ordenada.
Plano Terapéutico y Emocional
A nivel terapéutico y emocional, la A+ es valorada por su capacidad de mejorar el estado de ánimo y la percepción sensorial de forma manejable. Su perfil equilibrado la hace útil para exploración creativa, socialización consciente y primeras aproximaciones al autoconocimiento. Su potencia por encima de la media la hace más interesante que las cubensis más básicas para entornos terapéuticos iniciales, sin perder accesibilidad.
Advertencias y Perfil de Usuario
Apta para principiantes e intermedios. Se recomienda comenzar con dosis moderadas dado que su potencia está por encima de la media. Mantener siempre un entorno seguro y cómodo.
Impacto Cultural
La A+ es una de las cepas de referencia introducidas por la comunidad micológica online, siendo parte de la historia de Shroomery.org desde sus inicios. Su excepcional producción de esporas la ha convertido en favorita de vendedores y coleccionistas, consolidándola como pilar del cultivo de cubensis.
Ventajas y Limitaciones
Ventajas:
Potencia por encima de la media, alta producción de esporas, cultivable por principiantes e intermedios, sombreros grandes y vistosos, buena adaptabilidad a distintas condiciones.
Limitaciones:
La contaminación puede dificultar los flushes posteriores al primero. Visuales moderados, menos intensos que cepas más avanzadas.
Conclusión
La A+ es una cubensis clásica introducida por Mr. G en Shroomery.org que combina accesibilidad en el cultivo con una potencia por encima de la media. Su generosa producción de esporas y su perfil equilibrado la convierten en una opción ideal para quienes buscan dar un paso más allá de las cubensis más básicas.
🌍 Valor educativo y cultural
Estos productos son una herramienta útil para entender mejor la ecología de los hongos y su papel en la naturaleza, además de conectar con una tradición etnomicológica que ha acompañado a distintas culturas a lo largo de la historia.
⚠️ Nota importante
El uso de estos productos debe hacerse siempre dentro del marco legal de cada país y con un enfoque educativo y de observación micológica.
Comparativa Final: A+ frente a otras cepas populares
| Característica | A+ | B+ | Golden Teacher | Blue Meanie | Albino Tidal Wave | Melmac | Penis Envy |
|---|---|---|---|---|---|---|---|
| Potencia | Por encima de la media | Media | Media-alta | Media-alta | Muy alta | Muy alta | Muy alta |
| Dificultad cultivo | Principiante–intermedio | Muy baja | Baja | Media | Intermedio–avanzado | Avanzado | Alta |
| Morfología | Dorados con verrugas, tallos delgados | Sombreros grandes, robustos | Dorada y elegante | Azul intenso, mediana | Albina mutada | Deformes, potentes | Caps densos, tallos gruesos |
| Efectos | Equilibrados, por encima de media | Suaves y equilibrados | Introspectivos | Visuales eufóricos | Profundos | Intensos | Extremadamente intensos |
| Uso ideal | Principiantes–intermedios | Principiantes | Introspección | Intermedios/avanzados | Expertos | Expertos | Muy experimentados |
| Rendimiento | Bueno (óptimo en 1er flush) | Bueno | Alto | Alto | Alto | Medio–alto | Medio–bajo |
| Temp/Humedad | 24–28°C / 20–24°C, 90–95% HR | Similar | Similar | Similar | Similar | Similar | Similar |

Valoraciones
No hay valoraciones aún.